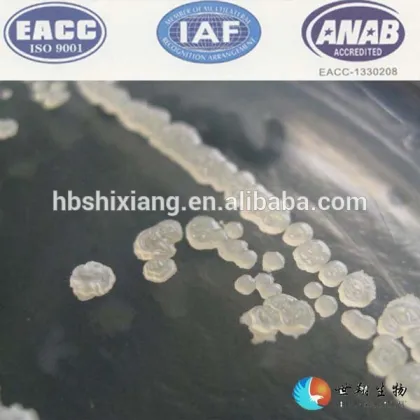
bacillus subtilis fermentation 200 billion CFU/g

Billion Polyester
Brand Introduction
The Advantages Of Billion Polyester:
Billlion Group, also known as Fujian Billion Polymerization Fiber Technology Industrial Co., Ltd., is a leading Chinese manufacturer specializing in polyester products, particularly in the field of differentiated polyester fibers. Established in 2003 and headquartered in Jinjiang, Fujian Province, the company has grown into one of the largest producers of polyester fibers globally.
Billlion Group focuses on innovation and technological advancement, offering a wide range of high-quality products such as polyester filaments, staple fibers, and non-woven fabrics. These materials are widely used in industries including textiles, apparel, home furnishings, automotive, and industrial applications.
The company is committed to sustainable development, integrating eco-friendly practices into its production processes. With a strong emphasis on research and development, Billlion has established itself as a trusted brand in both domestic and international markets, serving clients across Asia, Europe, the Americas, and beyond.
Billlion's success is driven by its dedication to quality, customer satisfaction, and continuous innovation, making it a key player in the global polyester industry.
Billlion's brand culture is rooted in innovation, quality, and sustainability. As a leading manufacturer of advanced materials and industrial solutions, Billlion is committed to delivering cutting-edge products that meet the highest standards of performance and reliability. The company emphasizes a customer-centric approach, striving to understand and exceed the needs of its clients across various industries.
At the core of Billlion's culture is a dedication to continuous improvement and technological advancement. The company fosters a collaborative and inclusive work environment, encouraging employees to think creatively and push the boundaries of what is possible. Billlion also places a strong emphasis on environmental responsibility, integrating sustainable practices into its operations to minimize its ecological footprint.
Overall, Billlion's brand culture is defined by its unwavering commitment to excellence, innovation, and a sustainable future, making it a trusted partner in the global market.
Billion, a prominent brand under the BAIHONG group, has established significant brand influence in the global market. Known for its innovative solutions and high-quality products, Billion specializes in advanced materials and technologies, particularly in the fields of polyester, polyamide, and related industries. The brand is recognized for its commitment to sustainability, technological excellence, and customer-centric approach, which has earned it a strong reputation among international clients. Billion's global presence and consistent delivery of cutting-edge solutions have solidified its position as a trusted leader in the industry, driving growth and setting benchmarks for quality and innovation.
$2650.0000
- $
2650.0000
Metric Ton
Min.order : 1 Metric Ton
Kilogram
Min.order : 20 Kilogram
$2.2200
- $
2.2200
Bag/Bags
Min.order : 20 Bag/Bags
Kilogram
Min.order : 1 Kilogram
$3.2000
- $
4.0000
Piece/Pieces
$2
- $
10
Carton
Min.order : 300 Carton
$2150.0000
- $
2150.0000
Metric Ton
Min.order : 2050 Metric Ton
$0.1400
- $
0.1400
Piece/Pieces
Min.order : 75000 Piece/Pieces
Kilogram
Min.order : 1 Kilogram
$800.0000
- $
800.0000
Metric Ton
Min.order : 3 Metric Ton
$25
- $
40
Kilogram
Min.order : 2 Kilogram
Customizable Zimbabwe Banknotes: Gold Plated 100 Billion Trillion Quintillion Dollar Wholesale Offer
$0.4500
- $
0.7500
piece
Min.order : 1 piece
$10.21
- $
11.36
piece
Min.order : 50 piece
Related Brand:
XINFENGMING
, Far Eastern New Century Corporation (FENC)
, Supima
, XLA
, Kaneka
, Unifi
, Trevira CS
, Trevira
, Dacron
, Indorama Ventures
Related Industry:
Sodium hydroxide
, Sodium ash
, Propylene glycol
, Polyethylene
, Taurine
, Thermal oil
, Silicone oil
, Propylene oxide
, Liquid nitrogen
, Antibacterial masterbatch
, talcum powder
, Ink
, Resin
, catalyst
, Additives
, Plasticizer
, Emulsifier
, Defoaming agent
, Toughening agent
, Antioxidants
, Masking agent
, Dispersant
, Snow melting agent
, Desiccant
, Demulsifier
, Flame retardant
, Epoxy resin curing agent
, MDI polyurethane
, TDI polyurethane
, Aramid
, Spandex
, Nylon
, Flavors and flavors
, Masterbatch
, Titanium dioxide
, Calcium carbonate powder
, Silicone rubber
, Carbon black
, paraffin
, Chemical raw materials
, dye
, Industrial salt
, Industrial gases
, Industrial paint
, Electrophoretic paint
, Epoxy zinc-rich primer
, Three-proof paint
, Powder coating
Recommended Related Videos

Please Send Message
${inquiryTitle}